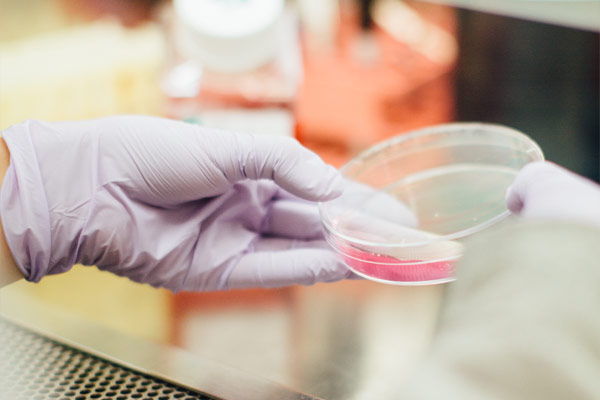

Your Medical Solution
Get powerful experience to create unique landing pages in just few minutes with R.Gen landing page toolkit

Awesome landing page for medical services
24/7 Services
Lorem ipsum dolor sit amet, consectetur adipisicing elit, sed do eiusmod tempor
Expert team
Lorem ipsum dolor sit amet, consectetur adipisicing elit, sed do eiusmod tempor
Emergency help
Lorem ipsum dolor sit amet, consectetur adipisicing elit, sed do eiusmod tempor
Our Departments
Lorem ipsum dolor sit amet, consectetur adipisicing elit, sed do eiusmod tempor incididunt ut labore et dolore magna aliqua. Ut enim ad minim veniam
What our customers say
Lorem ipsum dolor sit amet, consectetur adipisicing elit, sed do eiusmod tempor incididunt ut labore et dolore magna aliqua. Ut enim ad minim veniam, quis nostrud exercitation ullamco laboris nisi ut aliquip ex ea commodo
Oupsum dolor
Creative Director
Lorem ipsum dolor sit amet, consectetur adipisicing elit, sed do eiusmod tempor incididunt ut labore et dolore magna aliqua. Ut enim ad minim veniam, quis nostrud exercitation ullamco laboris nisi ut aliquip ex ea commodo
Oupsum dolor
Creative Director
Expert doctors with 24 hours services
Duis aute irure dolor in reprehenderit in voluptate velit esse cillum dolore eu fugiat nulla pariatur. Excepteur sint occaecat cupidatat non proident, sunt in culpa qui officia deserunt mollit anim id est laborum.
Book an AppointmentOur Professional Team
Our Achievements
Lorem ipsum dolor sit amet, consetetur sadipscing elitr diam nonumy eirmod tempor invidunt ut labore et dolore magna aliquyam
7456+
Happy smiles
20+
Years of experience
50+
Expert staff
Visit our clinic
PO Box 16122, Collins Street West, Victoria 8007, Australia
Give us a call
012 345 6789
Email us on
medical@rgen.com
Opening Hours
- Monday - Friday : 08:00 - 16:00
- Saturday : 08:00 - 16:00
- Sunday : 08:00 - 16:00
What are waiting for?